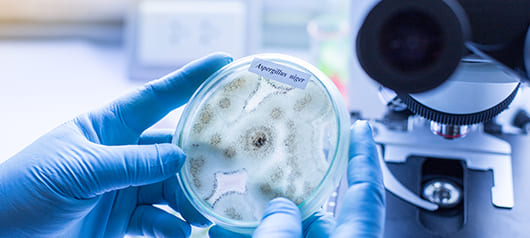
Какие факторы определяют эффективность профилактики аллергии?

Полный доступ для зарегистрированных пользователей
Полный доступ для зарегистрированных пользователей
Инновационные технологии в профилактике нарушений пищевой толерантности
Содержание
- Пищевая толерантность (ПТ)
- Факторы, способствующие нарушению формирования пищевой толерантности у детей раннего возраста1-4,12.
- Уникальная технология гидролиза
- NAN® Гипоаллергенный 1 производится по запатентованной эксклюзивной технологии
- Частично гидролизованный белок Optipro® HA
- NAN® Гипоаллергенный1
Какой фактор не учитывается при выборе смеси для профилактики аллергии к белкам коровьего молока?
Пищевая толерантность (ПТ)
– защитный механизм поддержания адекватного иммунного ответа на антигены пищи при сохранении физиологических защитных реакций против патогенов.
Факторы, способствующие нарушению формирования пищевой толерантности у детей раннего возраста1-4,12.

Первичная профилактика аллергии на белки коровьго молока (АБКМ) — комплекс мероприятий, направленных на предотвращение развития аллергии1-5,12,13.
Детям с высоким риском развития атопических заболеваний при отсутствии грудного молока для первичной профилактики пищевой аллергии рекомендованы детские молочные смеси на основе частично гидролизованного белка с доказанной клинической эффективностью1,12.
В настоящее время существует большое количество смесей на основе частично гидролизованного белка, различающихся между собой способом получения белкового компонента, составом пептидного профиля и самое главное — эффективностью в профилактике АБКМ.
Особенности технологии гидролиза белка определяют пептидный профиль и эффективность в формировании пищевой толерантности и в профилактике аллергии к белкам коровьего молока2,7.
Уникальная технология гидролиза
Если белок разрезан в неправильной точке, гидролизат не имеет превентивного эффекта

NAN® Гипоаллергенный 1 производится по запатентованной эксклюзивной технологии
и содержит уникальный частично гидролизованный белок Optipro® HA, обладающий высокими толерогенными свойствами5,14 и доказанной клинической эффективностью в профилактике АБКМ2,5,8-10,14.
Частично гидролизованный белок Optipro® HA
создан на основе сывороточного белка коровьего молока по особой технологии путем двухступенчатого гидролиза с тщательно выверенным временем процесса и ферментов, применяющихся для обработки исходного сырья5.

Частично гидролизованный белок Optipro® HA
имеет уникальный пептидный профиль, на 75% отличающийся от пептидов других частично гидролизованных смесей7.

Уникальность
пептидного профиля определяет эффективность

Эффективность
должна быть клинически доказана
* - Число пептидов в смесях на основе
частично гидролизованного белка.

NAN® Гипоаллергенный1
Единственная в мире смесь с профилактической эффективностью и клинически доказанным снижением риска развития аллергии у детей с младенчества до взрослого возраста**2, 7-11
на 52%
снижается риск развития атопического дерматита на первом году жизни ребенка и на 41% — к 20-му году жизни
на 33%
снижается риск развития аллергического ринита к 15 годам жизни.
на 55%
снижается риск развития бронхиальной астмы в период 16-20 лет жизни.

NAN® Гипоаллергенный 1 — доказанное снижение риска развития атопического дерматита от младенческого и до взрослого возраста14

C рождения
**GINI (German Infant Nutritional Intervention) Немецкое широкомасштабное независимое долгосрочное рандомизированное с двойным слепым контролем клиническое исследование профилактического воздействия гидролизатов на развитие аллергии у детей из групп повышенного риска развития аллергии (3 метаанализа, 20 научных публикаций. Период наблюдения за детьми составлял до 20 лет). На старте: 2252 ребенка, разделенных на 4 группы в соответствии с назначенными смесями для искусственного вскармливания: стандартная молочная смесь (СМС), частично гидролизованная смесь на основе сывороточных белков (ЧГС), высокогидролизованная смесь на основе казеина (ВГК) и высокогидролизованная смесь на основе сывороточных белков (ВГС). По результатам 1-го года выявлено достоверное снижение риска развития атопии у детей из групп ВГК и ЧГС, а также снижение сенсибилизации к пищевым антигенам.
АБКМ — аллергия на белки коровьего молока. НА — Гипоаллергенный.
Смесь NAN® Гипоаллергенный 1 OPTIPRO® HA — с рождения. Необходима консультация специалиста.
Источники:
1. Программа оптимизации вскармливания детей первого года жизни в Российской Федерации. Методические рекомендации ФГАУ «НМИЦ здоровья детей» Минздрава России. М.: б. и., 2019.
2. Украинцев С. Е. Профилактика аллергии: от иммунологии беременности до вскармливания детей первых месяцев жизни. Вопросы современной педиатрии. 2016.
3. Макарова С.Г. Лаврова Т.Е., Вишнева Е.А.,Турти Т.В., Акоев Ю.С. , Петровская М.И. Первичная профилактика как эффективный ответ на эпидемию аллергических болезней. Педиатрическая фармакология. 2015.
4. Ревякина В. А., Гамалея А. В. Профилактика пищевой аллергии у детей с риском атопии // Лечащий врач. 2006. № 1. URL: https://www.lvrach.ru/2006/01/4533289 (дата обращения: 19.01.2026).
5. Нетребенко О.К. Аллергия или пищевая толерантность: два пути развития иммунной системы. Педиатрия. 2010.
6. С.Г. Макарова, М.Н. Болдырева, Т.Е. Лаврова, М.И. Петровская Кишечный микробиоценоз, пищевая толерантность и пищевая аллергия. Современное состояние проблемы. Вопросы современной педиатрии. 2014.
7. Материалы видеолекций с ресурса https://www.nestlebaby.ru/medical/spravochnye-materialy-dlya-specialistov.
8. Ревякина В.А., Филатова Т.А., Боровик Т.Э., Гамалеева А.В, Сенцова Т.Б., Нетребенко О.К., Булай А.И. Диетопрофилактика аллергических заболеваний у детей из группы высокого риска развития атопии. Вопросы современной педиатрии. 2007.
9. Szajewska H, Horvath A. Meta-analysis of the evidence for a partially hydrolyzed 100% whey formula for the prevention of allergic diseases. Curr Med Res Opin. 2010.
10. Нетребенко О.К., Украинцев С. Е. Аллергия или пищевая толерантность: выбор профилактической смеси. Питание здорового и больного ребенка. Педиатрия. 2016.
11. Gappa M., Filipiak-Pittroff B., Libuda L. et al. Long-term effects of hydrolyzed formulae on atopic diseases in the GINI study. Allergy. 2021.
12. Федеральные клинические рекомендации по оказанию медицинской помощи детям с аллергией к белкам коровьего молока. 2015 г.
13. Боровик Т.Э, Макарова С.Г., Дарчия С.Н., Гамалеева А.В. Роль смесей — гидролизатов белка в профилактике и диетотерапии пищевой аллергии у детей раннего возраста. Вопросы современной педиатрии. 2010.
14. Berg A von, Koletzko S, Grubl A et al. GINI. German International Nutrition Intervention Study. Nestle Nutrition Workshop series, 2003.
15. Мачарадзе Д. Ш. Атопический дерматит и пищевая аллергия. Что общего? // Лечащий врач. 2013. № 5. URL: https://www.lvrach.ru/2013/05/15435700 (дата обращения: 19.01.2026).
Наш сайт в формате приложения всегда под рукой!
Нажмите на кнопку ниже и запустите установку приложения на следующей странице. При первом входе приложение запросит у вас разрешение на уведомления. Пожалуйста, нажмите «Да», если разрешаете приложению Nestle Baby&me Medical отправлять рекламные и информационные уведомления.
НачатьПриложение запросит у вас разрешение на уведомления. Пожалуйста, нажмите «Да», если разрешаете приложению Nestle Baby&me Medical отправлять рекламные и информационные уведомления.
Хорошо- 1. Нажмите на значок «Поделиться», он находится рядом с адресной строкой.
- 2. Выберите «Добавить на главный экран» и нажмите «Добавить».
ПАМЯТКА!
календарь вакцинации